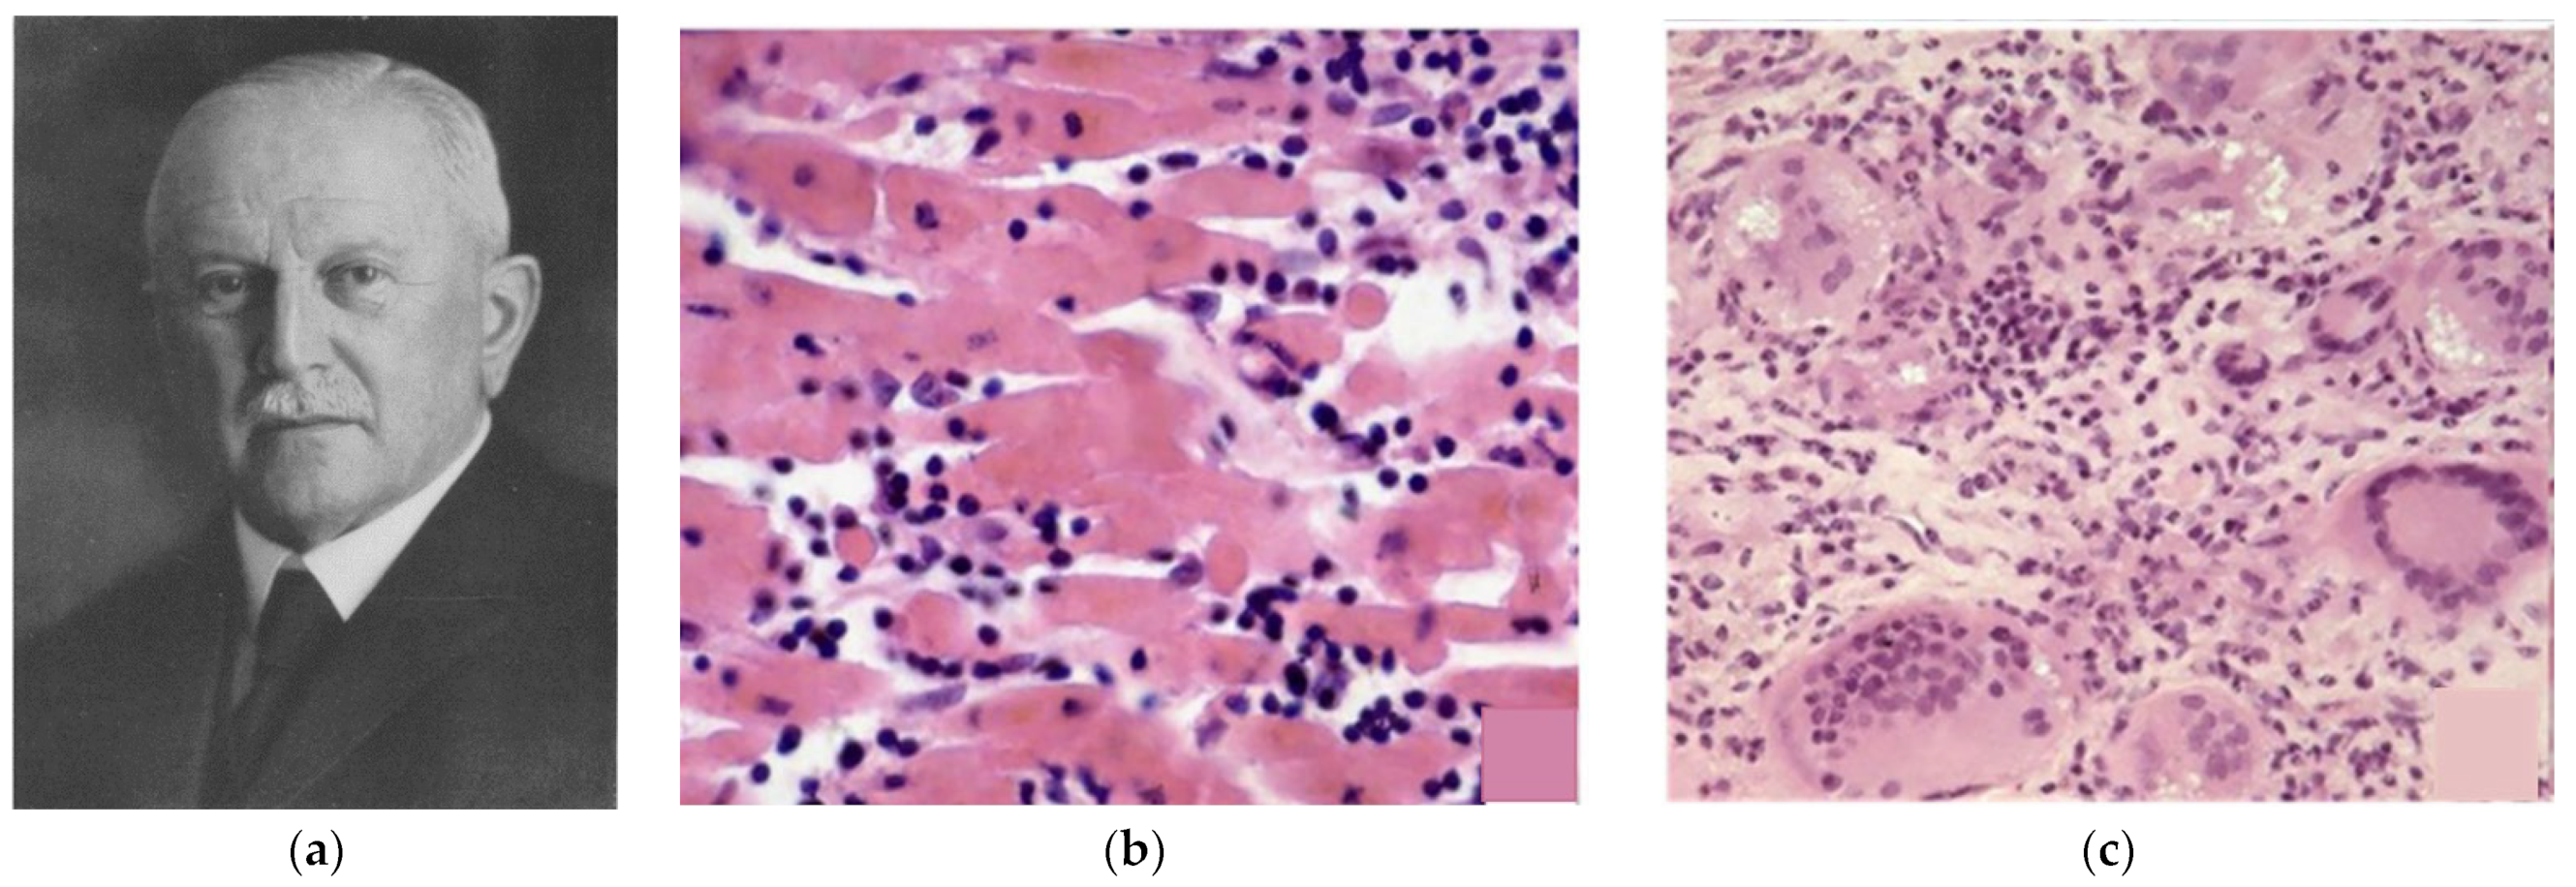

Storytelling of Myocarditis
Abstract
1. Introduction
- (1)
- Direct viral myocardial injury.
- (2)
- Secondary immune-mediated myocardial damage.
- (3)
- Myocardial scarring with remodeling, leading to dilated cardiomyopathy [14].




2. Highlights
- -
- Viral genomes can be detected in the myocardium of patients through endomyocardial biopsy with molecular analysis.
- -
- Edema is regularly associated with inflammation due to myocarditis and nowadays is specifically detected by Cardiac Magnetic Resonance with late enhancement.
- -
- Enterovirus infection may result in cytoskeletal lysis with cell death, entailing a severe prognosis.
- -
- Fulminant myocarditis with severe non-ischemic pump failure can heal with temporary support of myocardial contractility using ECMO, until spontaneous recovery.
- -
- The possibility of viral vaccination should be pursued.
3. Conclusions
| 1665 | Hooke R. Micrographia, or some physiological descriptions of minute bodies provided by magnifying glasses. [1] |
| 1900 | Fiedler A. Acute interstitial Myocarditis in sudden heart failure. [2] |
| 1904 | Aschoff KAL. Acute myocarditis in the setting of rheumatic pancarditis. [3] |
| 1928 | Chagas C. Sur les alteration du Coeur dans la trypanosomiases américaine. [6] |
| 1929 | Forssmann W. Die Sondierung des rechten Herzens [Probing the right heart]. [19] |
| 1929 | Bernstein M et al. Sarcoid: report of a case with visceral involvement. [7] |
| 1948 | Dalldorf G et al. An Unidentified, Filtrable Agent Isolated From the Feces of Children. [8] |
| 1962 | Sakakibara S and Konno S. Endomyocardial biopsy technique. [20] |
| 1980 | Woodruff JF. Viral myocarditis: a review. [10] |
| 1986 | Mullis KB et al. Process for amplifying, detecting, and/or-cloning nucleic acid sequences. [25] |
| 1986 | Bowles NE et al. Detection of coxsackie-B-virus specific RNA sequences in myocardial biopsy samples from patients with myocarditis and dilated cardiomyopathy. [26] |
| 1987 | Aretz HT et al. Myocarditis: a histopathologic definition and classification. [23] |
| 1991 | Lieberman EB et al. Clinicopathologic description of fulminant myocarditis. [31] |
| 1996 | Richardson P et al. WHO/ISFC Cardiomyopathies Classification and Definition. [12] |
| 1999 | Badorff C et al. Enteroviral protease 2A cleaves dystrophin: evidence of cytoskeletal disruption in an acquired cardiomyopathy. [31] |
| 1999 | Kawai C. From myocarditis to cardiomyopathy: mechanisms of inflammation and cell death: learning from the past for the future. [14] |
| 2001 | He Y. et al. Interaction of coxsackievirus B3 with the full length coxsackievirus-adenovirus receptor. [32] |
| 2003 | Frustaci A et al. Immunosuppressive therapy for active lymphocytic myocarditis: virological and immunologic profile of responders versus nonresponders. [11] |
| 2009 | Friedereich MG et al. Cardiovascular magnetic resonance in myocarditis. [28] |
| 2013 | Caforio A et al. Current state of knowledge on aetiology, diagnosis, management, and therapy of myocarditis: a position statement of the European Society of Cardiology. [29] |
| 2013 | Thiene G et al. Diagnostic use of the endomyocardial biopsy: a consensus statement. [27] |
Funding
Conflicts of Interest
References
- Hooke, R. Micrographia, or, Some Physiological Descriptions of Minute Bodies Made by Magnifying Glasses with Observations and Inquiries Thereupon; Martyn, J., Allestry, J., Eds.; Royal Society: London, UK, 1665. [Google Scholar]
- Fiedler, A. Uber akute interstitielle Myokarditis. Zentralblatt Inn. Med. 1900, 21, 212. [Google Scholar]
- Abramov, S.S. On the casuistry of the primary myocarditidis. Med. Obozr. Mosc. 1897, 48, 889–898. [Google Scholar]
- Saltykow, S. Uber diffuse Myokarditis. Virchows Arch. Patholologische Anat. 1905, 182, 1–39. [Google Scholar] [CrossRef]
- Aschoff, K.A.L. Zur Myocardiitisfrage. Verhandlungen Dtsch. Pathol. Ges. Stuttg. 1904, 8, 46–53. [Google Scholar]
- Chagas, C. Sur les alteration du Coeur dans la trypanosomiases américaine (maladie de Chagas). Arch. Mal. Coeur 1928, 21, 641–655. [Google Scholar]
- Bernstein, M.; Konzelmann, F.; Sidlick, D. Boeck’s Sarcoid: Report of a case with visceral involvement. Ann. Int. Med. 1929, 44, 721–734. [Google Scholar] [CrossRef]
- Dalldorf, G.; Sickles, G.M. An Unidentified, Filtrable Agent Isolated from the Feces of Children with Paralysis. Science 1948, 108, 61–62. [Google Scholar] [CrossRef]
- Saphir, O. Myocarditis. A general review, with an analysis of 240 cases. Arch. Path. 1941, 33, 88. [Google Scholar]
- Woodruff, J.F. Viral myocarditis: A Review. Am. J. Pathol. 1980, 101, 427–779. [Google Scholar]
- Frustaci, A.; Chimenti, C.; Calabrese, F.; Pieroni, M.; Thiene, G.; Maseri, A. Immunosuppressive therapy for active lymphocytic myocarditis: Virological and immunologic profile of responders versus nonresponders. Circulation 2003, 107, 857–863. [Google Scholar]
- Richardson, P.; McKenna, W.; Bristow, M.; Maisch, B.; Mautner, B.; O’Connell, J.; Olsen, E.; Thiene, G.; Goodwin, J.; Gyarfas, I.; et al. Report of the 1995 World Health Organization/International Society and Federation of Cardiology Task Force on the Definition and Classification of cardiomyopathies. Circulation 1996, 93, 841–842. [Google Scholar]
- Peretto, G.; Sala, S.; Rizzo, S.; Palmisano, A.; Esposito, A.; De Cobelli, F.; Campochiaro, C.; De Luca, G.; Foppoli, L.; Dagna, L.; et al. Ventricular Arrhythmias in Myocarditis: Characterization and Relationships with Myocardial Inflammation. J. Am. Coll. Cardiol. 2020, 75, 1046–1057. [Google Scholar] [CrossRef] [PubMed]
- Kawai, C. From myocarditis to cardiomyopathy: Mechanisms of inflammation and cell death: Learning from the past for the future. Circulation 1999, 99, 1091–1100. [Google Scholar] [CrossRef]
- Basso, C.; Thiene, G.; Corrado, D.; Angelini, A.; Nava, A.; Valente, M. Arrhythmogenic right ventricular cardiomyopathy. Dysplasia, dystrophy, or myocarditis? Circulation 1996, 94, 983–991. [Google Scholar] [CrossRef] [PubMed]
- Bariani, R.; Cipriani, A.; Rizzo, S.; Celeghin, R.; Marinas, M.B.; Giorgi, B.; De Gaspari, M.; Rigato, I.; Leoni, L.; Zorzi, A.; et al. ‘Hot phase’ clinical presentation in arrhythmogenic cardiomyopathy. Europace 2021, 23, 907–917. [Google Scholar] [CrossRef] [PubMed]
- Brodehl, A.; Belke, D.D.; Garnett, L.; Martens, K.; Abdelfatah, N.; Rodriguez, M.; Diao, C.; Chen, Y.X.; Gordon, P.M.; Nygren, A.; et al. Transgenic mice overexpressing desmocollin-2 (DSC2) develop cardiomyopathy associated with myocardial inflammation and fibrotic remodeling. PLoS ONE 2017, 12, e0174019. [Google Scholar] [CrossRef] [PubMed]
- Dennert, R.; Crijns, H.J.; Heymans, S. Acute viral myocarditis. Eur. Heart J. 2008, 29, 2073–2082. [Google Scholar] [CrossRef] [PubMed]
- Forssmann, W. Die Sondierung des rechten Herzens [Probing of the right heart]. Klin Wochenschr 1929, 8, 2085–2087. [Google Scholar] [CrossRef]
- Sakakibara, S.; Konno, S. Endomyocardial biopsy. Jpn. Heart J. 1962, 3, 537–543. [Google Scholar] [CrossRef] [PubMed]
- Frey, N.; Meder, B.; Katus, H. Left Ventricular Biopsy in the Diagnosis of Myocardial Diseases. Circulation 2018, 137, 993–995. [Google Scholar] [CrossRef]
- Ferrans, V.J.; Roberts, W.C. Myocardial biopsy: A useful diagnostic procedure or only a research tool? Am. J. Cardiol. 1978, 41, 965–967. [Google Scholar] [CrossRef]
- Aretz, H.T.; Billingham, M.E.; Edwards, W.D.; Factor, S.M.; Fallon, J.T.; Fenoglio, J.J., Jr.; Olsen, E.G.; Schoen, F.J. Myocarditis: A histopathologic definition and classification. Am. J. Cardiovasc. Pathol. 1987, 1, 3–14. [Google Scholar] [PubMed]
- Baughman, K.L. Diagnosis of myocarditis: Death of Dallas criteria. Circulation 2006, 113, 593–595. [Google Scholar] [CrossRef] [PubMed]
- Mullis, K.B.; Erlich, H.A.; Gelfand, D.H.; Horn, G.; Saiki, R.K. Process for Amplifying, Detecting, and/or-Cloning Nucleic Acid Sequences. U.S. Patent 4,683,195, 1986. [Google Scholar]
- Bowles, N.E.; Richardson, P.J.; Olsen, E.G.; Archard, L.C. Detection of coxsackie-B-virus specific RNA sequences in myocardial biopsy samples from patients with myocarditis and dilated cardiomyopathy. Lancet 1986, 17, 1120–1123. [Google Scholar] [CrossRef] [PubMed]
- Thiene, G.; Bruneval, P.; Veinot, J.; Leoni, O. Diagnostic use of the endomyocardial biopsy: A consensus statement. Virchows Arch. 2013, 463, 1–5. [Google Scholar] [CrossRef] [PubMed]
- Friedrich, M.G.; Sechtem, U.; Schulz-Menger, J.; Holmvang, G.; Alakija, P.; Cooper, L.T.; White, J.A.; Abdel-Aty, H.; Gutberlet, M.; Prasad, S.; et al. Cardiovascular magnetic resonance in myocarditis: A JACC White Paper. J. Am. Coll. Cardiol. 2009, 53, 1475–1487. [Google Scholar] [CrossRef] [PubMed]
- Caforio, A.L.; Pankuweit, S.; Arbustini, E.; Basso, C.; Gimeno-Blanes, J.; Felix, S.B.; Fu, M.; Heliö, T.; Heymans, S.; Jahns, R.; et al. Current state of knowledge on aetiology, diagnosis, management, and therapy of myocarditis: A position statement of the European Society of Cardiology Working Group on Myocardial and Pericardial Diseases. Eur. Heart J. 2013, 34, 2636–2648. [Google Scholar] [CrossRef]
- Lieberman, E.B.; Hutchins, G.M.; Herskowitz, A.; Rose, N.R.; Baughman, K.L. Clinicopathologic description of myocarditis. J. Am. Coll. Cardiol. 1991, 18, 1617–1626. [Google Scholar] [CrossRef]
- Badorff, C.; Lee, G.H.; Lamphear, B.J.; Martone, M.E.; Campbell, K.P.; Rhoads, R.E.; Knowlton, K.U. Enteroviral protease 2A cleaves dystrophin: Evidence of cytoskeletal disruption in an acquired cardiomyopathy. Nat. Med. 1999, 5, 320–326. [Google Scholar] [CrossRef]
- He, Y.; Chipman, P.R.; Howitt, J.; Bator, C.M.; Whitt, M.A.; Baker, T.S.; Kuhn, R.J.; Anderson, C.W.; Freimuth, P.; Rossmann, M.G. Interaction of coxsackievirus B3 with the full length coxsackievirus-adenovirus receptor. Nat. Struct. Biol. 2001, 8, 874–878. [Google Scholar] [CrossRef]
- Zhang, L.; Parham, N.J.; Zhang, F.; Aasa-Chapman, M.; Gould, E.A.; Zhang, H. Vaccination with coxsackievirus B3 virus-like particles elicits humoral immune response and protects mice against myocarditis. Vaccine 2012, 30, 2301–2308. [Google Scholar] [CrossRef]
- Yun, S.H.; Lee, W.G.; Kim, Y.C.; Ju, E.S.; Lim, B.K.; Choi, J.O.; Kim, D.K.; Jeon, E.S. Antiviral activity of coxsackievirus B3 3C protease inhibitor in experimental murine myocarditis. J. Infect Dis. 2012, 205, 491–497. [Google Scholar] [CrossRef]
- Cooper, L.T., Jr.; Berry, G.J.; Shabetai, R. Idiopathic giant-cell myocarditis—Natural history and treatment. Multicenter Giant Cell Myocarditis Study Group Investigators. N. Engl. J. Med. 1997, 336, 1860–1866. [Google Scholar] [CrossRef] [PubMed]
- Duncan, B.W.; Bohn, D.J.; Atz, A.M.; French, J.W.; Laussen, P.C.; Wessel, D.L. Mechanical circulatory support for the treatment of children with acute fulminant myocarditis. J. Thorac. Cardiovasc. Surg. 2001, 122, 440–448. [Google Scholar] [CrossRef] [PubMed]
- Teele, S.A.; Allan, C.K.; Laussen, P.C.; Newburger, J.W.; Gauvreau, K.; Thiagarajan, R.R. Management and outcomes in pediatric patients presenting with acute fulminant myocarditis. J. Pediatr. 2011, 158, 638–643.e1. [Google Scholar] [CrossRef] [PubMed]
- Diddle, J.W.; Almodovar, M.C.; Rajagopal, S.K.; Rycus, P.T.; Thiagarajan, R.R. Extracorporeal membrane oxygenation for the support of adults with acute myocarditis. Crit. Care Med. 2015, 43, 1016–1025. [Google Scholar] [CrossRef]
- Lorusso, R.; Centofanti, P.; Gelsomino, S.; Barili, F.; Di Mauro, M.; Orlando, P.; Botta, L.; Milazzo, F.; Actis Dato, G.; Casabona, R.; et al. GIROC Investigators. Venoarterial Extracorporeal Membrane Oxygenation for Acute Fulminant Myocarditis in Adult Patients: A 5-Year Multi-Institutional Experience. Ann. Thorac. Surg. 2016, 101, 919–926. [Google Scholar] [CrossRef]
- Lee, G.H.; Badorff, C.; Knowlton, K.U. Dissociation of sarcoglycans and the dystrophin carboxyl terminus from the sarcolemma in enteroviral cardiomyopathy. Circ. Res. 2000, 87, 489–495. [Google Scholar] [CrossRef]

| Viruses | DNA: Adenovirus, Herpes virus (cytomegalovirus, Epstein–Barr virus, varicella-zoster, Human Herpes Virus 6), Hepatitis B, Parvovirus B19 |
| RNA: Arbovirus, Hepatitis C virus, Picornavirus (entero, rhino), Orthomyxovirus (influenza A,B), Paramyxovirus (rubeola, mumps, respiratory syncytial virus), Retrovirus (HIV-1) | |
| Bacteria | Staphylococcus, Streptococcus, Pneumococcus, Meningococcus, Gonococcus, Salmonella, Corynebacterium diphtheriae, Hemophilus influenzae, Mycoplasma pneumoniae, Brucella species |
| Mycobacteria | Tuberculosis, Avium intracellular, Leprae |
| Fungi | Aspergillus, Candida, Actinomyces, Blastomyces, Cryptococcus, Histoplasma |
| Protozoa | Toxoplasma gondii, Trypanosoma cruzi |
| Rickettsiae | Coxiella burnetti (Q fever), Rickettsia rickettsii, Rickettsia tsutsugamuschi |
| Chlamydia | Trachomatis, Pittaci |
| Parasitic | Trichinella spiralis |
Disclaimer/Publisher’s Note: The statements, opinions and data contained in all publications are solely those of the individual author(s) and contributor(s) and not of MDPI and/or the editor(s). MDPI and/or the editor(s) disclaim responsibility for any injury to people or property resulting from any ideas, methods, instructions or products referred to in the content. |
© 2024 by the author. Licensee MDPI, Basel, Switzerland. This article is an open access article distributed under the terms and conditions of the Creative Commons Attribution (CC BY) license (https://creativecommons.org/licenses/by/4.0/).
Share and Cite
Thiene, G. Storytelling of Myocarditis. Biomedicines 2024, 12, 832. https://doi.org/10.3390/biomedicines12040832
Thiene G. Storytelling of Myocarditis. Biomedicines. 2024; 12(4):832. https://doi.org/10.3390/biomedicines12040832
Chicago/Turabian StyleThiene, Gaetano. 2024. "Storytelling of Myocarditis" Biomedicines 12, no. 4: 832. https://doi.org/10.3390/biomedicines12040832
APA StyleThiene, G. (2024). Storytelling of Myocarditis. Biomedicines, 12(4), 832. https://doi.org/10.3390/biomedicines12040832
